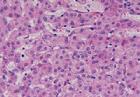
急性間歇性卟啉病

概述
 急性間歇性卟啉病
急性間歇性卟啉病急性間歇性卟啉病(acuteintermittentporphyria,AIP)亦稱肝性卟啉病吡咯卟啉病是卟啉病中較多見的一種1911年,由Gunther首先報導,Waldenstrom在1937年廣泛家族研究的基礎上,全面描述了本病。臨床特徵為腹部絞痛、頑固性便秘精神症狀和尿中排泄大量ALA及卟膽原。發病率因地區不同而不同,國外的總發病情況大約占人口的1.5/10萬,瑞典高達1/1.3萬美國發病率5/10萬~10/10萬。男女均可發病,女性比男性多見(占60%~70%)。發病年齡大多在20~40歲,兒童期開始起病者極少見。
病因
 常染色體
常染色體1.尿卟啉原合成酶部分缺乏即卟膽原脫氨酶缺陷引起。患者的此酶活性大約只有正常人的50%。
2.常染色體顯性遺傳用核酸原位雜交等技術已確定卟膽原脫氨酶的基因位於11q23-qter區域,含有5個外顯子。
3.卟膽原脫氨酶至少有3種不同的同工酶已知一種存在於所有組織中,另一種只存在於紅細胞中但缺陷雖然在這些組織和紅細胞存在,但其功能上的表現似乎僅限於肝臟。
4.常在青春期發病月經期易誘發發作。某些藥物和激素能誘發本病發作或使病情加重是因能促進肝臟中ALA合成酶的作用糖類和正鐵血紅素ALA合成酶有暫時的抑制作用。
發病機制
肝細胞
肝細胞本病為常染色體顯性遺傳位於11號染色體11q24上卟膽原脫氨酶等位基因發生突變,患者肝細胞、淋巴、皮膚、上皮羊膜及紅細胞內卟膽原脫氨酶活性僅為正常人50%致使卟膽原轉為尿卟啉原途徑受阻,同時由於ALA合成活性增強表現卟膽原和ALA在體內蓄積研究報導這種基因突變至少有4種類型,因而酶活性表現不一有些酶的免疫活性及催化生物活性減低有些免疫活性正常,催化活性減低。此外,因有的患者紅細胞內酶活性正常,而其他組織內減低。證明很可能控制酶表達的不止1個等位基因,控制紅細胞為1個基因,控制其他組織內酶表達的為另1個基因。
本病患者代謝異常與神經系統症狀間關係目前還不十分明了。研究發現,卟膽原和ALA對神經系統有毒性作用。以ALA作用為主。包括:①抑制神經肌肉接頭傳導介質釋放,體外培養可引起神經和腦細胞壞死;②抑制性神經傳導介質γ-氨基丁酸受體的強興奮劑;③遺傳性酪氨酸血症患者和嚴重缺乏ALA脫水酶患者的ALA均過量蓄積,其發生的神經系統症狀與本病相似;④神經系統內血紅素合成缺陷,體外細胞培養試驗表明抑制血紅素合成可使細胞嚴重退化,投予血紅素後可抑制本病的神經系統症狀。多數雜合子基因攜帶者缺乏症狀,但某些因素可促進其發病。
臨床表現
急性發作約有60%可找到誘因,如飲酒感染月經期、飢餓等。某些藥物也可誘發,有鎮靜安眠藥、抗癲癇藥、降糖藥、磺胺藥灰黃黴素女性激素和某些避孕藥等,妊娠和分娩也可引起發作。
大多數患者腹痛是其主要的症狀,發作性的絞痛可輕可重,但大多較嚴重,甚至難以忍受。疼痛部位可以是局限的或波及整個腹部,或放射至背部、腰部或外生殖器不伴有腹肌緊張和腹膜刺激征。查體時腹部大多沒有明顯壓痛除略有脹氣外,很少陽性發現發作時間自數小時至數天或數周不等。一次或多次不規則發作伴有噁心、嘔吐、頑固性便秘、腹脹。急性發作的持續時間和次數很不一致。有些病人僅仍然有間歇性輕微腹痛但有些初次發作就病勢兇險很快死亡。
神經系統方面的症狀可以多種多樣周圍神經受累類似末梢神經炎有四肢神經痛、痛覺減退或麻木感,但檢查時痛覺的消失較少見可因肌力減退,出現運動方面的症狀,如肌無力垂腕、垂足或四肢鬆弛性癱瘓都有可伴有肌肉劇痛,特別是小腿。受累肌群可發生萎縮,肌腱反射減低或消失,但緩解時又可恢復。末梢神經的累及兩側可不對稱。腹部、肋間或膈肌癱瘓導致呼吸麻痹或呼吸停止。上運動神經元癱瘓罕見。累及腦神經出現眼肌麻痹、視神經萎縮、面神經癱瘓、聲嘶、呃逆和吞咽困難等症狀。自主神經症狀以竇性心動過速是經常存在的症狀之一,與迷走神經病變有關,短暫高血壓亦多見。精神方面有性格改變,神經衰弱,癔症樣發作,不少病人在急性發作之前常有精神緊張煩躁不安、容易激動,甚至出現幻覺、狂躁、語無倫次等。個別病人可暫時失明,最嚴重者可發生驚厥,甚至昏迷。發作時腦電圖可出現癲癇或電解質不平衡的變化。神經精神症和心動過速不少病人可被誤診為神經官能症或癔症,甚至被認為有意誇大症狀。
患者的父親或母親及兄弟姊妹中有時可發現尿中含有過多的卟膽原但可能從來沒有明顯的症狀,這種情況稱為隱性卟啉病。上述急性症狀包括腹痛、末梢神經炎、精神失常及紫紅色尿,有人稱為“4P”。癲癇發作是急性發作少見的併發症,可由低鈉、低鎂或卟啉本身對神經膠質細胞作用引起
診斷
 腹部絞痛
腹部絞痛鑑別診斷:
應與以下情況鑑別:
1.遇有腹痛,注意與各種急腹症鑑別如腎結石、膽囊膽總管結石、急性胰腺炎、胃或十二指腸潰瘍、急性闌尾炎、腸梗阻等,甚至因此而誤施行外科手術。
2原因不明的神經系統的功能紊亂特別是出現末梢神經症狀、機體局部的肌無力、癱瘓等,應特別注意卟啉病的可能。
3.中毒患者也有腹痛、便秘和神經系統症狀尿中ALA的排泄也是增多的,但二甲氨基苯甲醛試驗的結果通常為陰性,應注意鑑別。
疾病檢查
 白細胞
白細胞實驗室檢查:
1.血象外周血象沒有明顯異常。急性發作時白細胞計數常常增高。
2.尿液檢查急性發作期尿中卟膽原和δ-氨基酮戊酸大量增加尿呈咖啡色剛排出的尿顏色大多正常,在體外或日光下暴露片刻或置酸性環境下尿逐漸變成暗紅色或咖啡色。直接日光照射時,甚至變成黑色。
3.二甲氨基苯甲醛試驗尿液卟膽原試驗陽性。二甲氨基苯甲醛試驗(Watson-Schwartz試驗)是檢查卟膽原一種簡單可靠的方法。尿中的卟膽原與二甲氨基苯甲醛(Ehrlich醛試劑)發生反應而變成深紅色但尿中的尿膽原或吲哚與此試劑也產生紅色,但這兩種物質加氯仿或丁醇振搖後,紅色被這種溶劑提去,而卟膽原的紅色仍在尿液中。本病急性發作時,此試驗經常呈強陽性反應緩解期有時也可以陽性。隱性病人此試驗的結果可呈現弱陽性或陰性。對此種反應陰性的病人必須用層析法定量測定尿中ALA及卟膽原,方可做出診斷。尿中的卟膽原本無色,曝光後變為尿卟啉或糞卟啉呈紅色。此時產生的尿卟啉有特殊的光譜Wood光照下紅色螢光。尿滯留24h後卟膽原試驗可呈假陰性。糞中糞卟啉含量大多在正常範圍內或輕度至中等度增加。紅細胞卟膽原脫氨酶的活性降至正常人的50%左右。
4.其他檢查急性發作時,血鈉常趨過低。肝功能試驗大多正常但磺溴酞鈉排泄可以滯留。
其它輔助檢查:
根據臨床表現症狀、體徵可選擇做B超、X線、心電圖、腦電圖、CT等檢查。
治療
 嗎啡
嗎啡1.控制腹痛可用嗎啡應避免使用有害藥物,特別是巴比妥及磺胺類藥物。吩噻嗪類藥物可用作症狀治療氯丙嗪25mg,4次/d,可有效控制疼痛及精神症狀。
2.每天葡萄糖300~500g靜脈或口服,可使ALA合成酶受抑制,使患者尿中ALA和卟膽原排出減少部分患者可減輕發作症狀。
3.血紅素治療如患者24h內症狀無改善,可用正鐵血紅素治療。套用劑量4mg/kg,12h內均勻輸注。如大劑量快速輸注可致急性腎功能衰竭。
4.癲癇發作的治療是急性發作少見併發症,可由低鈉、低鎂或卟啉本身對神經膠質細胞作用引起。溴劑和硫酸鎂可能有效,糾正電解質紊亂可控制癲癇發作。
預後及預防
預後:如果注意積極的防治,預後不一定很嚴重。1966年以前,22%急性發作的病人死亡,死亡病例大多是30歲以前的青年死因往往是呼吸麻痹和心律失常1966年以後,急性發作的死亡僅占5.1%,1979年後,急性發作期很少死亡。隨著年齡的增長,本病傾向於減輕,預後較好。
預防:避免使用有可能誘發急性發作藥物如巴比妥等,是最有效的預防措施。

